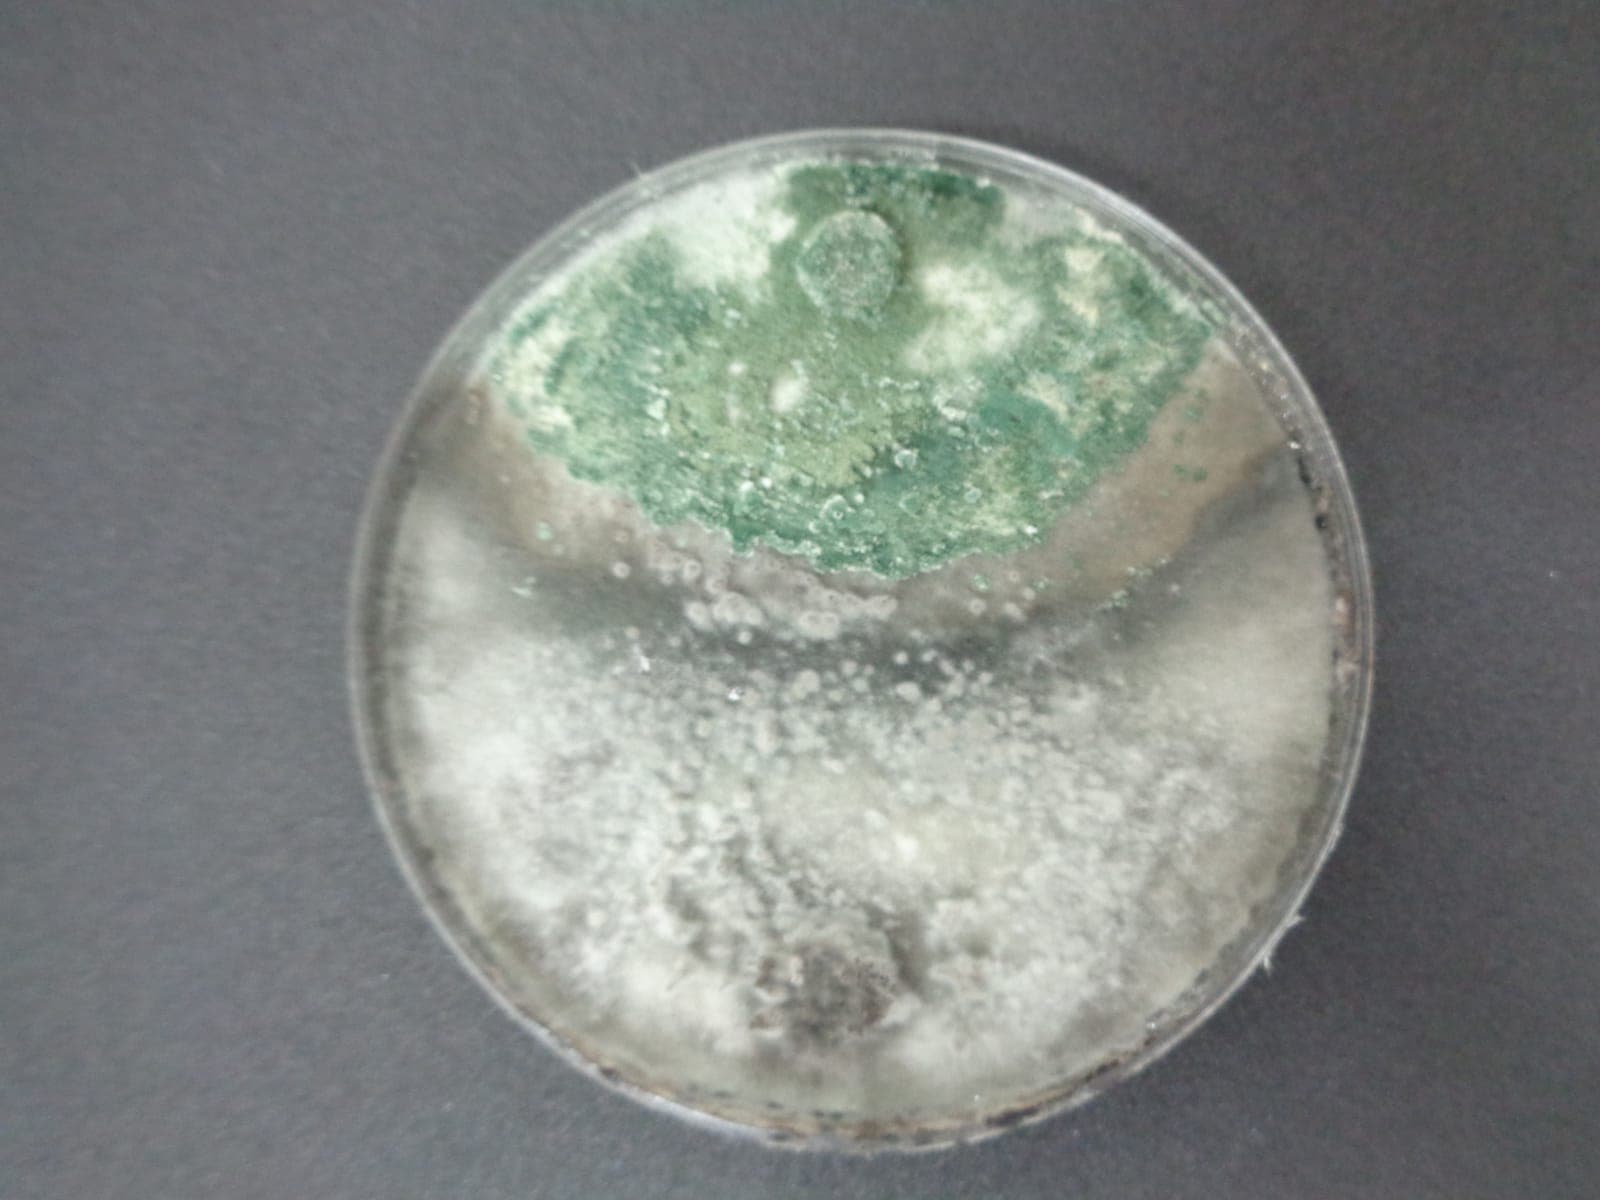
Colonia de Trichoderma en PDA

Catalogo Morfologico
Galeria visual interactiva con microscopias, colonias y sintomatologia. Filtra por categoria y haz clic para ver detalles cientificos.

Microscopia de Colletotrichum
Colletotrichum spp.PatogenoColonia de Trichoderma en PDA
Trichoderma spp.BiocontrolColonia madura de Trichoderma
Trichoderma spp.Biocontrol
Antracnosis en hojas de maracuya
Passiflora edulisSintomatologiaColonia de Trichoderma en PDA
Trichoderma spp.BiocontrolAntracnosis en frutos de maracuya
Passiflora edulisSintomatologia
Manchado de calices de jamaica
Corynespora cassiicolaPatogenoMostrando 7 imagenes · Fotografia: Santo Angel OA